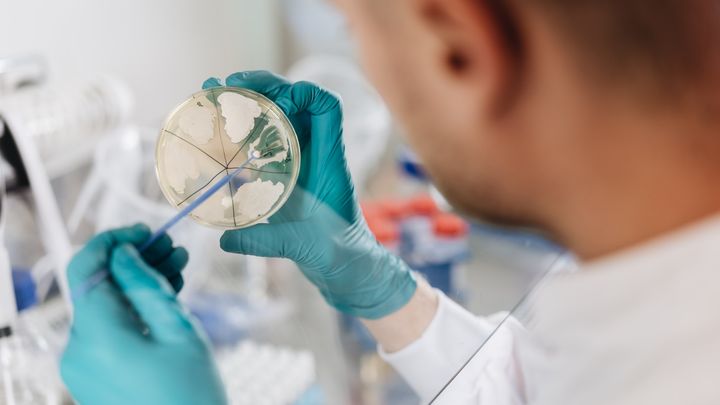
Størstedelen af de danske patentansøgninger er indenfor feltet bioteknologi, hvor DTU er blandt de førende forskningsinstitutioner i verden. Foto: Kasper Løjtved

DTU er det mest patentsøgende universitet i Europa
24.3.2026 06:30:00 CET | DTU - Danmarks Tekniske Universitet | Pressemeddelelse
113 gange i 2025 søgte DTU patent på en ny teknologi opfundet af en ansat forsker. Dermed stiger universitetet helt til tops på en ny opgørelse fra Det Europæiske Patentkontor.
Når en forsker knækker koden til en helt ny teknologi og vil udvikle den kommercielt, er det vigtigt at andre ikke bare kan kopiere idéen. Derfor hjælper DTU ofte med at beskytte innovation fra universitetet med et patent.
I 2025 er det sket 113 gange, hvilket er flere end på noget andet universitet i Europa – inklusive store og prestigefyldte institutioner som EPFL (103) og ETH Zurich (81) i Schweitz og britiske Oxford (52). Også danske KU og AU er i top 10 i Europa med henholdsvis 48 og 43 patenter. Det viser en ny opgørelse fra Det Europæiske Patentkontor, EPO.
”DTU har arbejdet systematisk og intensivt med innovation i mere end et årti. Og vi bliver ved, fordi Danmark og Europas fremtid afhænger af viljen og evnen til at skabe ny viden og bringe den ud i samfundet, hvor den kan gøre gavn,” siger DTU’s rektor, Anders Bjarklev.
Fakta
Se hele top 10-listen her.
Listen angiver de europæiske universiteter, som har indsendt flest patentansøgninger til Det Europæiske Patentkontor, EPO, i 2025.
- DTU - 113
- EPFL – École Polytechnique Fédérale de Lausanne - 103
- KU Leuven - 103
- ETH Zürich - 81
- TUM - Technische Universität München - 67
- Universiteit Gent - 55
- Oxford University - 52
- Københavns Universitet - 48
- Aarhus Universitet - 43
- Universität Zürich - 41
Udover at sammenligne de europæiske universiteter, har Det Europæiske Patentkontor også udgivet en liste over de danske virksomheder, der er mest patentaktive. Her indtager DTU en fjerdeplads, kun overgået af Novonesis (178 patenter), Vestas (132) og Topsoe (114).
Læs mere om opgørelsen over ansøgninger hos Det Europæiske Patentkontor.
Nøgleord
Kontakter
Anders Overgaard BjarklevRektorDTU
Tlf:+45 4525 1000dtu-rektor@adm.dtu.dkDTU Presse
Pressekontakten varetages alle hverdage fra kl. 9-16
DTU - Danmarks Tekniske Universitet
DTU er et teknisk eliteuniversitet med international rækkevidde og standard. Vores mission er at udvikle og nyttiggøre naturvidenskab og teknisk videnskab til gavn for samfundet.
Følg pressemeddelelser fra DTU - Danmarks Tekniske Universitet
Skriv dig op her, og modtag pressemeddelelser på e-mail. Indtast din e-mail, klik på abonner, og følg instruktionerne i den udsendte e-mail.
Flere pressemeddelelser fra DTU - Danmarks Tekniske Universitet
Imponerende stigning i kvote 2-ansøgere til DTU18.3.2026 09:56:19 CET | Pressemeddelelse
Antallet af kvote 2-ansøgere til både diplomingeniør- og bacheloruddannelserne på DTU er steget markant.
Ny rapport viser, hvordan Europa kan genvinde sit deeptech forspring5.3.2026 11:45:21 CET | Pressemeddelelse
Europa skaber forskning i verdensklasse, men alt for mange lovende teknologier når aldrig ud på markedet. En ny rapport fra DTU giver konkrete bud på, hvordan europæiske institutioner kan styrke deres indsats for skalering af nye teknologier.
DTU sætter fuld fart på uddannelse af erhvervskandidater26.2.2026 13:10:29 CET | Pressemeddelelse
Uddannelses- og Forskningsministeriet har givet grønt lys for at alle DTU’s 32 kandidatretninger kan optage studerende på den såkaldte 1+2-ordning, der åbner for mere fleksible, arbejdsmarkedsrettede kandidatveje.
Første kirurg ansat på DTU19.2.2026 10:00:35 CET | Pressemeddelelse
Overlæge Tobias Todsen fra Rigshospitalet er den første kirurg, der bliver ansat som klinisk professor på DTU. Med sig har han daglige erfaringer med at operere kræftpatienter – og erfaring som medstifter af en spinout virksomhed, der bygger på en 3D ultralydsteknologi til at forbedre præcision ved kræftkirurgi.
DTU udvider med ny forskningsbygning og markante investeringer i rumteknologi18.2.2026 09:37:14 CET | Pressemeddelelse
Som led i en markant DTU-investering i rum- og forsvarsområdet på omkring 2 mia. kr. over en femårig periode, blev der taget første spadestik til en betydelig udvidelse af aktiviteterne på DTU Space, Danmarks største rumforskningsinstitut.
I vores nyhedsrum kan du læse alle vores pressemeddelelser, tilgå materiale i form af billeder og dokumenter samt finde vores kontaktoplysninger.
Besøg vores nyhedsrum